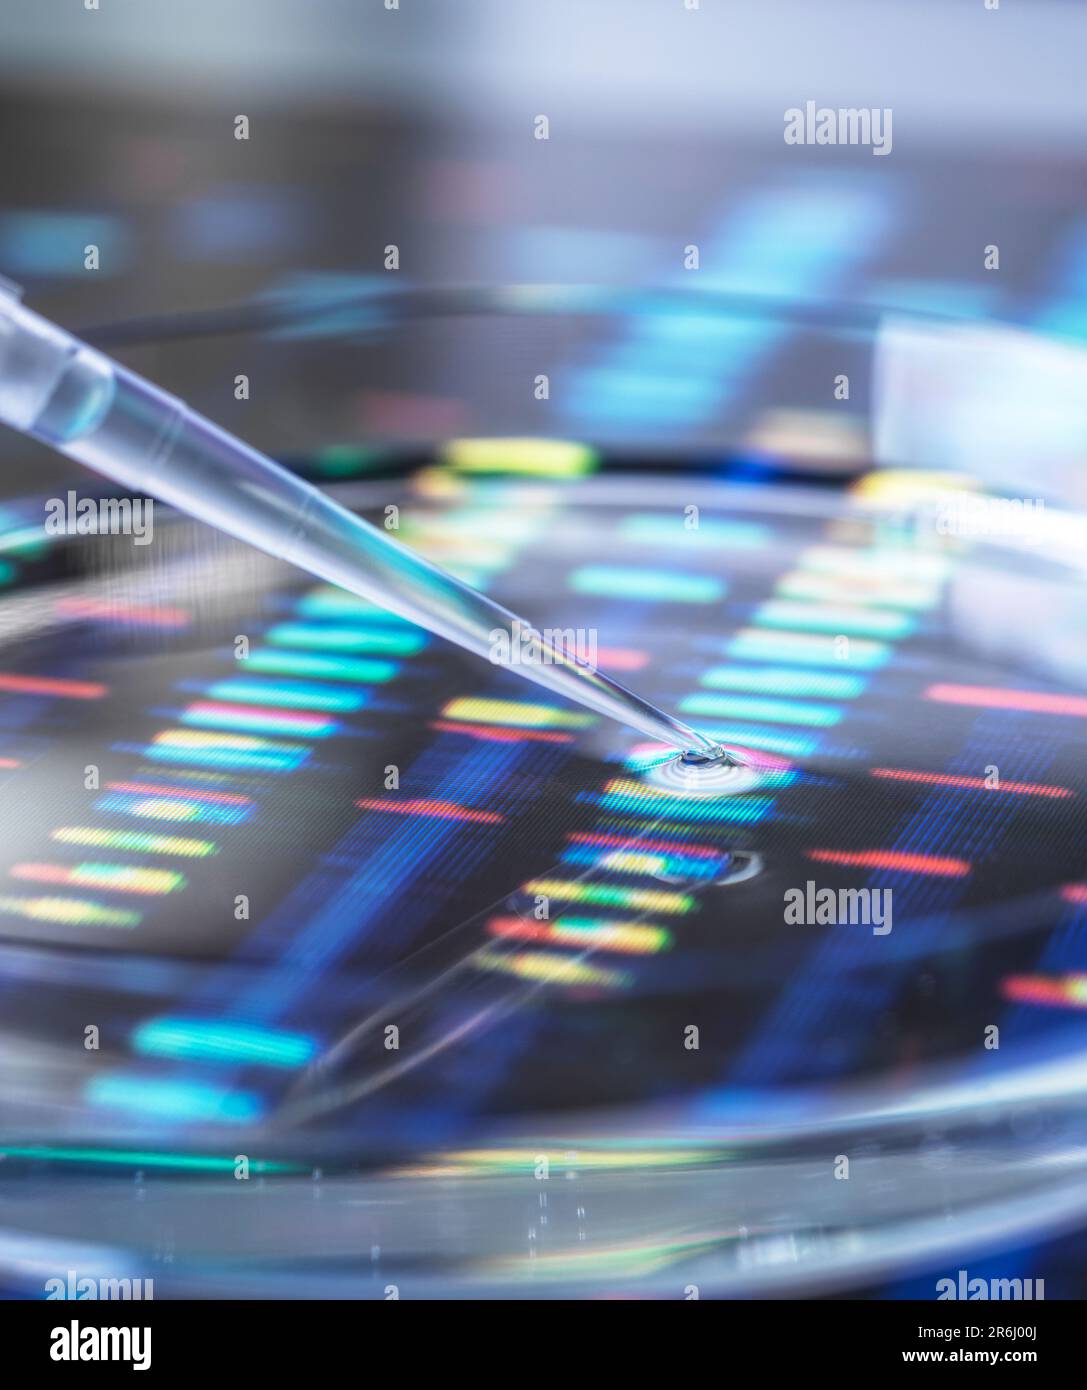
Genomforschung, Konzeptbild Stockfoto

Dna probenahme Stockfotos & Bilder

RFPEY8BG–Das zusammengesetzte Bild von DNA (Desoxyribonukleinsäure) Prüfergebnisse eines Eppendorf Röhrchen mit einer DNA-Probe.

RFPEY8BH–Das zusammengesetzte Bild von DNA (Desoxyribonukleinsäure) Prüfergebnisse eines Eppendorf Röhrchen mit einer DNA-Probe.

RFRBR4GR–Die genetische Forschung. Ein eppendorf Röhrchen mit einem DNA (Desoxyribonukleinsäure) Probe mit dem DNA-Profil im Hintergrund.

RFRBR4GW–Wissenschaftler Pipettieren eine DNA (Desoxyribonukleinsäure) Probe in eine Petrischale mit ein DNA-Profil im Hintergrund.

RFRBR4GX–Wissenschaftler Pipettieren eine DNA (Desoxyribonukleinsäure) Probe in eine Petrischale mit ein DNA-Profil im Hintergrund.

RFRBR4GN–Die genetische Forschung. Ein eppendorf Röhrchen mit einem DNA (Desoxyribonukleinsäure) Probe mit dem DNA-Profil im Hintergrund.

RFRBR4GM–Die genetische Forschung. Ein eppendorf Röhrchen mit einem DNA (Desoxyribonukleinsäure) Probe mit dem DNA-Profil im Hintergrund.

RFRBR4GY–Wissenschaftler Pipettieren eine DNA (Desoxyribonukleinsäure) Probe in eine Petrischale mit ein DNA-Profil im Hintergrund.

RFRBR4GP–Die genetische Forschung. Ein eppendorf Röhrchen mit einem DNA (Desoxyribonukleinsäure) Probe mit dem DNA-Profil im Hintergrund.

RFRBR4GT–Wissenschaftler Pipettieren eine DNA (Desoxyribonukleinsäure) Probe in eine Petrischale mit ein DNA-Profil im Hintergrund.

RFHY3BH0–Eine Probe von DNA (Desoxyribonukleinsäure) wird in eine Petrischale mit DNA pipettiert führt im Hintergrund.

RFHY3BGW–Eine Probe von DNA (Desoxyribonukleinsäure) wird in eine Petrischale mit DNA pipettiert führt im Hintergrund.

RFHY3BH2–Eine Probe von DNA (Desoxyribonukleinsäure) wird in eine Petrischale mit DNA pipettiert führt im Hintergrund.

RFHY3BH1–Eine Probe von DNA (Desoxyribonukleinsäure) wird in eine Petrischale mit DNA pipettiert führt im Hintergrund.

RFHY3BGT–Eine Probe von DNA (Desoxyribonukleinsäure) wird in eine Petrischale mit DNA pipettiert führt im Hintergrund.

RFHY3BHP–Ein Reagenzglas mit einer Probe vor DNA (Desoxyribonukleinsäure) Ergebnisse auf dem Bildschirm statt.

RFHY3BHM–Ein Reagenzglas mit einer Probe vor DNA (Desoxyribonukleinsäure) Ergebnisse auf dem Bildschirm statt.

RFHY3BHK–Ein Reagenzglas mit einer Probe vor DNA (Desoxyribonukleinsäure) Ergebnisse auf dem Bildschirm statt.

RF2YX6PYC–Wissenschaftler, der eine DNA-Probe (Desoxyribonukleinsäure) für die Analyse vorbereitet, mit einem DNA-Profil auf dem Bildschirm.

RFGF91K5–EIGENTUM FREIGEGEBEN. Eine Nadel, eine Probe von DNA (Desoxyribonukleinsäure) aus einem Fläschchen zu nehmen, während der Tests im Labor.

RFGF91K3–EIGENTUM FREIGEGEBEN. Eine Nadel, eine Probe von DNA (Desoxyribonukleinsäure) aus einem Fläschchen zu nehmen, während der Tests im Labor.

RFHY3BHC–Wissenschaftler halten ein Fläschchen mit einer DNA (Desoxyribonukleinsäure) Probe bereit für Gentests, mit DNA-Testergebnisse auf einem Bildschirm.

RFHY3BHD–Wissenschaftler halten ein Fläschchen mit einer DNA (Desoxyribonukleinsäure) Probe bereit für Gentests, mit DNA-Testergebnisse auf einem Bildschirm.

RFHY3BHA–Wissenschaftler halten ein Fläschchen mit einer DNA (Desoxyribonukleinsäure) Probe bereit für Gentests, mit DNA-Testergebnisse auf einem Bildschirm.

RFHY3BJ0–-MODELL VERÖFFENTLICHT. Wissenschaftler Pipettieren DNA (Desoxyribonukleinsäure) Probe in ein Fläschchen für die genetische Analyse bereit.

RFM15F3E–MODEL RELEASED. Wissenschaftler halten eine DNA (Desoxyribonukleinsäure) autoradiogram enthüllt die genetischen Make-up einer Probe.

RFPEY89R–Wissenschaftler halten eine DNA (Desoxyribonukleinsäure) Probe in ein Rohr mit der Ergebnisse auf einem DNA gel dargestellt.

RFPEY89T–Wissenschaftler halten eine DNA (Desoxyribonukleinsäure) Probe in ein Rohr mit der Ergebnisse auf einem DNA gel dargestellt.

RFWB2XX7–Genetik Forschung. Probe von DNA (Desoxyribonukleinsäure) in a multi-well Platte, mit einer DNA-Sequenz im Hintergrund.

RFWB2XXX–Genetik Forschung. Probe von DNA (Desoxyribonukleinsäure) in a multi-well Platte, mit einer DNA-Sequenz im Hintergrund.

RFWB2XW7–Genetik Forschung. Probe von DNA (Desoxyribonukleinsäure) in a multi-well Platte, mit einer DNA-Sequenz im Hintergrund.

RFWB2XXY–Genetik Forschung. Probe von DNA (Desoxyribonukleinsäure) in a multi-well Platte, mit einer DNA-Sequenz im Hintergrund.

RFWB2XW6–Genetik Forschung. Probe von DNA (Desoxyribonukleinsäure) in a multi-well Platte, mit einer DNA-Sequenz im Hintergrund.

RFWB2XTT–Genetik Forschung. Probe von DNA (Desoxyribonukleinsäure) in a multi-well Platte, mit einer DNA-Sequenz im Hintergrund.

RFWB2XRW–Konzeptionelle Bild zur Veranschaulichung der genetischen Forschung. Ein menschlicher Fingerabdruck mit einem DNA (Desoxyribonukleinsäure)-Profil unter einem menschlichen Probe in einer Petrischale.

RF2YX6PXK–Wissenschaftler, der eine DNA-Probe (Desoxyribonukleinsäure) für die Analyse vorbereitet, mit einem DNA-Profil auf dem Bildschirm.

RF2YX6PXP–Wissenschaftler, der eine DNA-Probe (Desoxyribonukleinsäure) für die Analyse vorbereitet, mit einem DNA-Profil auf dem Bildschirm.

RFWB2XW0–Genetik Forschung. Probe von DNA (Desoxyribonukleinsäure) in a multi-well Platte, mit einer DNA-Sequenz im Hintergrund.

RFWB2XRR–Konzeptionelle Bild zur Veranschaulichung der genetischen Forschung. Ein menschlicher Fingerabdruck mit einem DNA (Desoxyribonukleinsäure)-Profil unter einem menschlichen Probe in einer Petrischale.

RFWB2XTC–Konzeptionelle Bild zur Veranschaulichung der genetischen Forschung. Ein menschlicher Fingerabdruck mit einem DNA (Desoxyribonukleinsäure)-Profil unter einem menschlichen Probe in einer Petrischale.

RFWB2XRK–Konzeptionelle Bild zur Veranschaulichung der genetischen Forschung. Ein menschlicher Fingerabdruck mit einem DNA (Desoxyribonukleinsäure)-Profil unter einem menschlichen Probe in einer Petrischale.

RFGF91K2–EIGENTUM FREIGEGEBEN. Reihen von Proben-DNA (Desoxyribonukleinsäure) in einem Labor getestet werden.

RFWB2Y0K–Die biotechnologische Forschung. Wissenschaftler pipettieren Samples in eine Mikro-zentrifugenröhrchen bereit für die automatisierte Analyse.

RFWB2Y12–Die biotechnologische Forschung. Wissenschaftler pipettieren Samples in eine Mikro-zentrifugenröhrchen bereit für die automatisierte Analyse.

RFWB2Y07–Die biotechnologische Forschung. Wissenschaftler untersuchen Probe in einem Reagenzglas bereit für die automatisierte Analyse.

RFWB2Y0N–Die biotechnologische Forschung. Wissenschaftler untersuchen Probe in einem Reagenzglas bereit für die automatisierte Analyse.

RF2C9JYB2–Genetische Forschung. Ein eppendorf Fläschchen, das eine Probe auf einem DNA-Gel (Desoxyribonukleinsäure) enthält.

RF2C9JYAC–Wissenschaftler hält eine Probe vor einem DNA-Autoradiogramm (Desoxyribonukleinsäure) auf einem Leuchtkasten.

RF2C9JYCR–Wissenschaftler hält eine Probe vor einem DNA-Autoradiogramm (Desoxyribonukleinsäure) auf einem Leuchtkasten.

RFFCJ2HN–EIGENTUM FREIGEGEBEN. Genetische Forschung. DNA (Desoxyribonukleinsäure) Autoradiogram mit einer Probe in einer Petrischale, illustriert gen zu bearbeiten.

RFFCJ2HM–EIGENTUM FREIGEGEBEN. Genetische Forschung. DNA (Desoxyribonukleinsäure) Autoradiogram mit einer Probe in einer Petrischale, illustriert gen zu bearbeiten.

RFGF91K1–EIGENTUM FREIGEGEBEN. Reihen von Proben-DNA (Desoxyribonukleinsäure) in einem Labor getestet werden.

RF2C9JYD5–Genetische Forschung. Ein eppendorf Fläschchen, das eine Probe auf einem DNA-Gel (Desoxyribonukleinsäure) enthält.

RF2C9JYAK–Wissenschaftler hält eine Probe vor einem DNA-Autoradiogramm (Desoxyribonukleinsäure) auf einem Leuchtkasten.

RFFCJ2HG–Genetische Forschung. DNA (Desoxyribonukleinsäure) Autoradiogram mit einer Probe in einer Petrischale, illustriert gen zu bearbeiten.

RFFCJ2HR–EIGENTUM FREIGEGEBEN. Genetische Forschung. DNA (Desoxyribonukleinsäure) Autoradiogram mit einer Probe in einer Petrischale, illustriert gen zu bearbeiten.